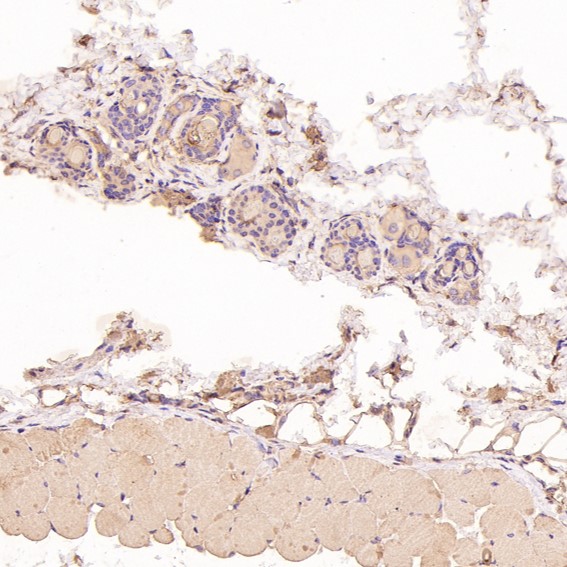
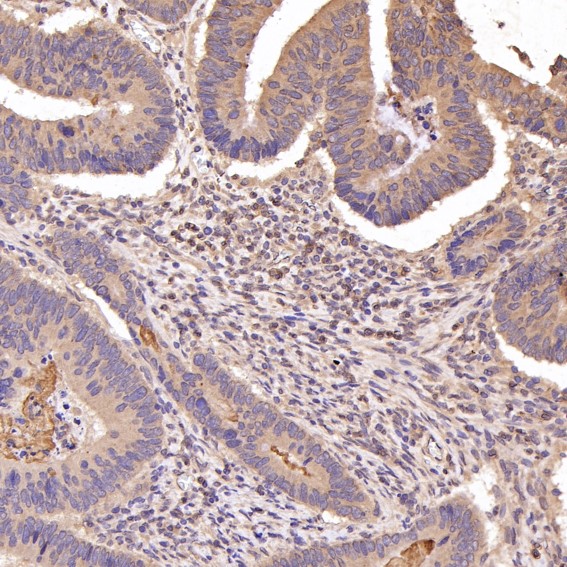

PTEN Antibody (CY5862)
References (1)
UniProt:P60484
Application:WB,IHC,ICC/IF
Reactivity:Human,Mouse,Rat
Source:Rabbit mAb
PTEN Antibody (CY5862)
UniProt:P60484
Application:WB,IHC,ICC/IF
Reactivity:Human,Mouse,Rat
Source:Rabbit mAb
References(1)
http://www.abways.cn/showproduct.asp?cid=CY5862
Phospho-PTEN (S380) Antibody (CY5849)
UniProt:P60484
Application:WB,ICC/IF
Reactivity:Human,Mouse,Rat
Source:Rabbit mAb
Phospho-PTEN (S380) Antibody (CY5849)
UniProt:P60484
Application:WB,ICC/IF
Reactivity:Human,Mouse,Rat
Source:Rabbit mAb
http://www.abways.cn/showproduct.asp?cid=CY5849
PTEN Antibody (CY5231)
References (2)
UniProt:P60484
Application:WB,IHC,ICC/IF,FC
Reactivity:Human,Mouse,Rat
Source:Rabbit mAb
PTEN Antibody (CY5231)
UniProt:P60484
Application:WB,IHC,ICC/IF,FC
Reactivity:Human,Mouse,Rat
Source:Rabbit mAb
References(2)
http://www.abways.cn/showproduct.asp?cid=CY5231
PTEN (7H2) Mouse mAb (AB3597)
UniProt:P60484
Application:IHC
Reactivity:Human
Source:Mouse mAb
http://www.abways.cn/showproduct.asp?cid=AB3597
Phospho-PTEN (Ser380/Thr382/Thr383) Antibody (AY0572)
UniProt:P60484
Application:WB,IHC
Reactivity:Human:S380+T382+T383,Mouse:S380+T382+T383,Rat:S380+T382+T383
Source:Rabbit pAb
暂无图片
Phospho-PTEN (Ser380/Thr382/Thr383) Antibody (AY0572)
UniProt:P60484
Application:WB,IHC
Reactivity:Human:S380+T382+T383,Mouse:S380+T382+T383,Rat:S380+T382+T383
Source:Rabbit pAb
http://www.abways.cn/showproduct.asp?cid=AY0572
Phospho-PTEN (Ser380) Antibody (AY0571)
UniProt:P60484
Application:IHC
Reactivity:Human:S380,Mouse:S380,Rat:S380
Source:Rabbit pAb
Phospho-PTEN (Ser380) Antibody (AY0571)
UniProt:P60484
Application:IHC
Reactivity:Human:S380,Mouse:S380,Rat:S380
Source:Rabbit pAb
http://www.abways.cn/showproduct.asp?cid=AY0571
PTEN Antibody (AY0570)
UniProt:P60484
Application:WB,IHC,ELISA
Reactivity:Human,Mouse,Rat
Source:Rabbit pAb
PTEN Antibody (AY0570)
UniProt:P60484
Application:WB,IHC,ELISA
Reactivity:Human,Mouse,Rat
Source:Rabbit pAb
http://www.abways.cn/showproduct.asp?cid=AY0570
Phospho-PTEN (Ser370) Antibody (CY6449)
UniProt:P60484
Application:WB,IHC
Reactivity:Human,Mouse,Rat
Source:Rabbit pAb
Phospho-PTEN (Ser370) Antibody (CY6449)
UniProt:P60484
Application:WB,IHC
Reactivity:Human,Mouse,Rat
Source:Rabbit pAb
http://www.abways.cn/showproduct.asp?cid=CY6449
< Prev1Next >

销售咨询
销售咨询 一键电话
一键电话